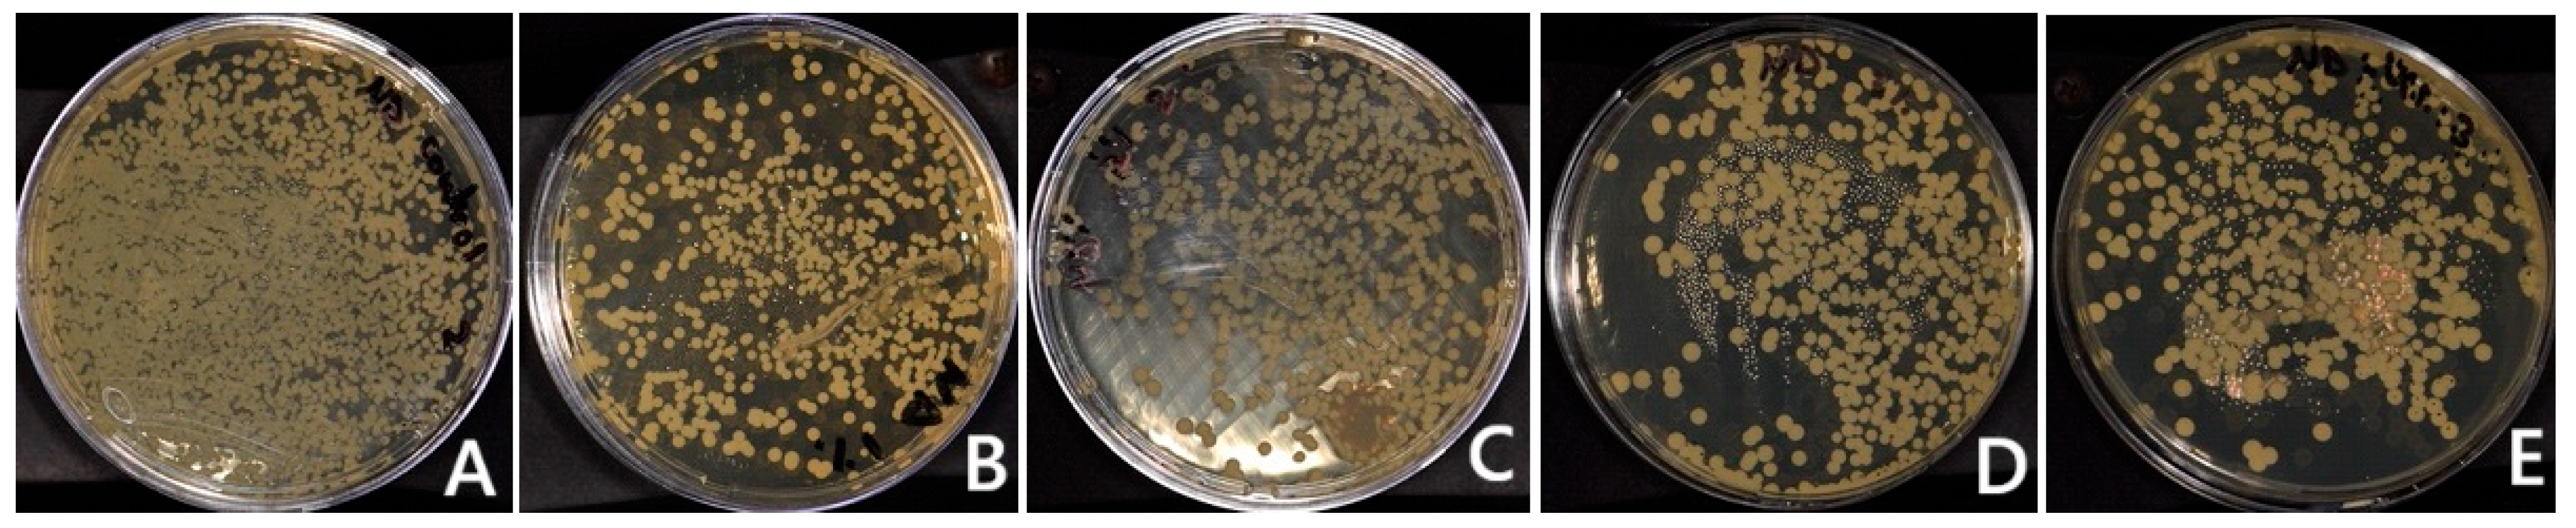
Polymers 17 01403 g003 Polymers 17 01403 g003

Antifungal Efficacy and Surface Properties of Conventional and 3D-Printed Denture Base Materials Modified with Titanium Tetrafluoride (TiF4): In Vitro Study
Abstract
1. Introduction
2. Materials and Methods
2.1. Sample Size Calculation
2.2. Specimens Grouping
2.3. Resin/TiF4 Mixture Preparation
2.3.1. HP/TiF4 Mixture
2.3.2. Three-Dimensional-Printed/TiF4 Mixture
2.4. Three-Dimensional-Printed Resin Specimens’ Preparation
2.5. HP Specimens’ Preparation
2.6. Specimens Polishing
2.7. Thermal Aging
2.8. Fourier-Transform Infrared (FTIR) Analysis
2.9. Specimen Testing
2.9.1. C. albicans Adherence Test (Colony Forming Unit, (CFU/mL))
2.9.2. Surface Roughness (µM) Test
2.9.3. Hardness (VHN) Test
2.9.4. Color Change (ΔE00) Test
2.10. Statistical Analysis
3. Results
3.1. C. albicans Adherence (CFU/mL)
3.2. FTIR
3.3. Surface Roughness
3.4. Hardness (VHN)
3.5. Color Change (ΔE00)
4. Discussion
Limitations and Recommendations
5. Conclusions
Author Contributions
Funding
Institutional Review Board Statement
Data Availability Statement
Conflicts of Interest
References
- Moussa, A.R.; Dehis, W.M.; Elboraey, A.N.; ElGabry, H.S. A Comparative Clinical Study of the Effect of Denture Cleansing on the Surface Roughness and Hardness of Two Denture Base Materials. Open Access Maced. J. Med. Sci. 2016, 4, 476–481. [Google Scholar] [CrossRef] [PubMed]
- Bahrani, F.; Vojdani, M.; Safari, A.; Karampoor, G. Comparison of Hardness and Surface Roughness of Two Denture bases Polymerized by Different Methods. World J. Dent. 2012, 3, 171–175. [Google Scholar] [CrossRef]
- Gautam, R.; Singh, R.D.; Sharma, V.P.; Siddhartha, R.; Chand, P.; Kumar, R. Biocompatibility of polymethylmethacrylate resins used in dentistry. J. Biomed. Mater. Res. Part B Appl. Biomater. 2012, 100, 1444–1450. [Google Scholar] [CrossRef] [PubMed]
- Akin, H.; Tugut, F.; Polat, Z.A. In vitro comparison of the cytotoxicity and water sorption of two different denture base systems. J. Prosthodont. 2014, 24, 152–155. [Google Scholar] [CrossRef] [PubMed]
- Alp, G.; Murat, S.; Yilmaz, B. Comparison of Flexural Strength of Different CAD/CAM PMMA-Based Polymers. J. Prosthodont. 2019, 28, e491–e495. [Google Scholar] [CrossRef]
- Alghazzawi, T.F. Advancements in CAD/CAM technology: Options for practical implementation. J. Prosthodont. Res. 2016, 60, 72–84. [Google Scholar] [CrossRef]
- jeffrey.stansbury@cuanschutz.edu. Available online: https://dental.cuanschutz.edu/faculty/facultydirectory/craniofacial-biology/Stansbury-Jeffrey-UCD10227 (accessed on 13 February 2024).
- Steinmassl, O.; Offermanns, V.; Stöckl, W.; Dumfahrt, H.; Grunert, I.; Steinmassl, P.A. In Vitro Analysis of the Fracture Resistance of CAD/CAM Denture Base Resins. Materials 2018, 11, 401. [Google Scholar] [CrossRef]
- Ahmad, M.N.; Tarmeze, A.A.; Rasib, A.H.A. Capability of 3D Printing Technology in Producing Molar Teeth Prototype. Int. J. Eng. Appl. (IREA) 2020, 8, 64. [Google Scholar] [CrossRef]
- Bidra, A.S.; Taylor, T.D.; Agar, J.R. Computer-aided technology for fabricating complete dentures: Systematic review of historical background, current status, and future perspectives. J. Prosthet. Dent. 2013, 109, 361–366. [Google Scholar] [CrossRef]
- Bidra, A.S.; Farrell, K.; Burnham, D.; Dhingra, A.; Taylor, T.D.; Kuo, C.-L. Prospective cohort pilot study of 2-visit CAD/CAM monolithic complete dentures and implant-retained overdentures: Clinical and patient-centered outcomes. J. Prosthet. Dent. 2016, 115, 578–586.e1. [Google Scholar] [CrossRef]
- Gad, M.M.; Fouda, S.M.; Abualsaud, R.; Alshahrani, F.A.; Al-Thobity, A.M.; Khan, S.Q.; Akhtar, S.; Ateeq, I.S.; Helal, M.A.; Al-Harbi, F.A. Strength and Surface Properties of a 3D-Printed Denture Base Polymer. J. Prosthodont. 2022, 31, 412–418. [Google Scholar] [CrossRef] [PubMed]
- Radford, D.; Challacombe, S.; Walter, J. Denture plaque and adherence of candida albicans to denture-base materials in vivo and in vitro. Crit. Rev. Oral Biol. Med. 1999, 10, 99–116. [Google Scholar] [CrossRef] [PubMed]
- Campos, M.S.; Marchini, L.; Bernardes, L.A.S.; Paulino, L.C.; Nobrega, F.G. Biofilm microbial communities of denture stomatitis. Oral Microbiol. Immunol. 2008, 23, 419–424. [Google Scholar] [CrossRef]
- Arendorf, T.M.; Walker, D.M. Denture stomatitis: A review. J. Oral Rehabil. 1987, 14, 217–227. [Google Scholar] [CrossRef]
- Douglas, W.H.; Walker, D.M. Nystatin in denture liners—An alternative treatment of denture stomatitis. Br. Dent. J. 1973, 135, 55–59. [Google Scholar] [CrossRef]
- Vanden Abbeele, A.; de Meel, H.; Ahariz, M.; Perraudin, J.P.; Beyer, I.; Courtois, P. Denture contamination by yeasts in the elderly. Gerodontology 2008, 25, 222–228. [Google Scholar] [CrossRef] [PubMed]
- Thomas, C.; Nutt, G.M. The in vitro fungicidal properties of Visco-gel, alone and combined with nystatin and amphotericin B. J. Oral Rehabil. 1978, 5, 167–172. [Google Scholar] [CrossRef]
- Nawasrah, A.; AlNimr, A.; Ali, A.A. Antifungal Effect of Henna against Candida albicans Adhered to Acrylic Resin as a Possible Method for Prevention of Denture Stomatitis. Int. J. Environ. Res. Public Health 2016, 13, 520. [Google Scholar] [CrossRef]
- Al-Thobity, A.M.; Al-Khalifa, K.S.; Gad, M.M.; Al-Hariri, M.; Ali, A.A.; Alnassar, T. In Vitro Evaluation of the Inhibitory Activity of Thymoquinone in Combatting Candida albicans in Denture Stomatitis Prevention. Int. J. Environ. Res. Public Health 2017, 14, 743. [Google Scholar] [CrossRef]
- Hamid, S.; Al-Dubayan, A.; Al-Awami, H.; Khan, S.; Gad, M. In vitro assessment of the antifungal effects of neem powder added to polymethyl methacrylate denture base material. J. Clin. Exp. Dent. 2019, 11, e170–e178. [Google Scholar] [CrossRef]
- Radford, D.; Sweet, S.; Challacombe, S.; Walter, J. Adherence of Candida albicans to denture-base materials with different surface finishes. J. Dent. 1998, 26, 577–583. [Google Scholar] [CrossRef] [PubMed]
- Abuzar, M.A.; Bellur, S.; Duong, N.; Kim, B.B.; Lu, P.; Palfreyman, N.; Surendran, D.; Tran, V.T. Evaluating surface roughness of a polyamide denture base material in comparison with poly (methyl methacrylate). J. Oral Sci. 2010, 52, 577–581. [Google Scholar] [CrossRef]
- Gungor, H.; Gundogdu, M.; Duymus, Z.Y. Investigation of the effect of different polishing techniques on the surface roughness of denture base and repair materials. J. Prosthet. Dent. 2014, 112, 1271–1277. [Google Scholar] [CrossRef] [PubMed]
- Şahin, O.; Koroglu, A.; Dede, D.Ö.; Yilmaz, B. Effect of surface sealant agents on the surface roughness and color stability of denture base materials. J. Prosthet. Dent. 2016, 116, 610–616. [Google Scholar] [CrossRef]
- Anderson, L.N.; Alsahafi, T.; Clark, W.A.; Felton, D.; Sulaiman, T.A. Evaluation of surface roughness of differently manufactured denture base materials. J. Prosthet. Dent. 2023, in press. [Google Scholar] [CrossRef]
- Arslan, E.; Akay, C.; Erdönmez, D.; Avukat, E.N. Evaluation of the effect of new generation denture base materials aged in artificial saliva at different pH levels on surface roughness and Candida albicans adhesion. BMC Oral Health 2025, 25, 356. [Google Scholar] [CrossRef] [PubMed]
- Sepúlveda-Navarro, W.F.; Arana-Correa, B.E.; Borges, C.P.F.; Jorge, J.H.; Urban, V.M.; Campanha, N.H. Color stability of resins and nylon as denture base material in beverages. J. Prosthodont. 2011, 20, 632–638. [Google Scholar] [CrossRef]
- Fouda, S.M.; Gad, M.M.; Ellakany, P.; El Zayat, M.; Farooqi, F.A.; Akhtar, S.; Salah El-Din, M. Influence of denture brushing on the surface properties and color stability of CAD-CAM, thermoformed, and conventionally fabricated denture base resins. J. Prosthodont. 2025, 34, 91–100. [Google Scholar] [CrossRef]
- Sagsoz, N.P.; Yanıkoglu, N.; Ulu, H.; Bayındır, F. Color Changes of Polyamid and Polymetyhl Methacrylate Denture Base Materials. Open J. Stomatol. 2014, 4, 489–496. [Google Scholar] [CrossRef]
- Meriç, G.; Güvenir, M.; Suer, K. Effectiveness of non-fluoride and fluoride dentifrices for denture hygiene. Acta Odontol. Scand. 2017, 75, 437–441. [Google Scholar] [CrossRef]
- Alcântara, P.C.d.C.; Alexandria, A.K.; de Souza, I.P.R.; Maia, L.C. In situ effect of titanium tetrafluoride and sodium fluoride on artificially decayed human enamel. Braz. Dent J. 2014, 25, 28–32. [Google Scholar] [CrossRef][Green Version]
- Vieira, A.; Ruben, J.; Huysmans, M. Effect of titanium tetrafluoride, amine fluoride and fluoride varnish on enamel erosion in vitro. Caries Res. 2005, 39, 371–379. [Google Scholar] [CrossRef] [PubMed]
- Vieira, A.; Lugtenborg, M.; Ruben, J.; Huysmans, M. Brushing abrasion of eroded bovine enamel pretreated with topical fluorides. Caries Res. 2006, 40, 224–230. [Google Scholar] [CrossRef] [PubMed]
- Magalhães, A.C.; Dos Santos, M.G.; Comar, L.P.; Buzalaf, M.A.R.; Ganss, C.; Schlueter, N. Effect of a Single Application of TiF4 Varnish versus Daily Use of a Low-Concentrated TiF4/NaF Solution on Tooth Erosion Prevention in vitro. Caries Res. 2016, 50, 462–470. [Google Scholar] [CrossRef]
- Sharafeddin, F.; Koohpeima, F.; Razazan, N. The Effect of Titanium Tetrafluoride and Sodium Hypochlorite on the Shear Bond Strength of Methacrylate and Silorane Based Composite Resins: An In-Vitro Study. J. Dent. Shiraz Iran 2017, 18, 82–87. [Google Scholar]
- Elsaka, S.E.; Elnaghy, A.M. Bonding durability of titanium tetrafluoride treated glass fiber post with resin cement. Dent. Mater. J. 2019, 38, 189–195. [Google Scholar] [CrossRef]
- de Souza, B.M.; Fernandes Neto, C.; Salomão, P.M.A.; de Vasconcelos, L.R.S.M.; de Andrade, F.B.; Magalhães, A.C. Analysis of the antimicrobial and anti-caries effects of TiF4 varnish under microcosm biofilm formed on enamel. J. Appl. Oral Sci. 2018, 26, e20170304. [Google Scholar] [CrossRef]
- Abbatepaulo, G.L.; Gangana, T.M.M.C.; Martinez, E.F.; Turssi, C.P.; França, F.M.G.; Amaral, F.L.B.; Basting, R.T. TiF4 Incorporated into a Self-etching Primer in Different Concentrations: Antimicrobial Properties and Effects on Demineralisation Inhibition Around the Restoration/Enamel-Dentin Interface. Oral Health Prev. Dent. 2019, 17, 57–67. [Google Scholar] [CrossRef]
- Eskandarian, T.; Motamedifar, M.; Arasteh, P.; Eghbali, S.S.; Adib, A.; Abdoli, Z. Comparison of antimicrobial effects of titanium tetrafluoride, chlorhexidine, xylitol and sodium fluoride on streptococcus mutans: An in-vitro study. Electron. Physician 2017, 9, 4042–4047. [Google Scholar] [CrossRef]
- Ates, M.; Akdeniz, B.G.; Sen, B.H. The effect of calcium chelating or binding agents on Candida albicans. Oral Surg. Oral Med. Oral Pathol. Oral Radiol. Endodontol. 2005, 100, 626–630. [Google Scholar] [CrossRef]
- Albazroun, Z.; Alabdullatif, A.; Aldehaileb, S.; Alhalimi, F.; Alshahrani, F.A.; Khan, S.Q.; Fouda, S.M.; AlRumaih, H.S.; Gad, M.M. Bond Strength of Nanocomposite Hard Liner to CAD-CAM Milled, 3D Printed, and Conventionally Fabricated Denture Base Resins. Dent. J. 2024, 12, 275. [Google Scholar] [CrossRef] [PubMed]
- Lin, C.-H.; Lin, Y.-M.; Lai, Y.-L.; Lee, S.-Y. Mechanical properties, accuracy, and cytotoxicity of UV-polymerized 3D printing resins composed of Bis-EMA, UDMA, and TEGDMA. J. Prosthet. Dent. 2020, 123, 349–354. [Google Scholar] [CrossRef] [PubMed]
- Al-Dulaijan, Y.A. Evaluation of the Effects of Different Polishing Protocols on the Surface Characterizations of 3D-Printed Acrylic Denture Base Resins: An In Vitro Study. Polymers 2023, 15, 2913. [Google Scholar] [CrossRef]
- Gad, M.M.; Khattar, A.; Alramadan, D.M.; Al Dawood, Z.H.; Al Shehab, S.S.; Al Zaher, R.H.; Alzain, L.O.; Khan, S.Q.; Abdelfattah, M.Y. Nanoparticle-Modified 3D-Printed Denture Base Resins: Influence of Denture Cleansers on the Color Stability and Surface Roughness In Vitro. Nanomaterials 2024, 14, 891. [Google Scholar] [CrossRef]
- AlGhamdi, M.A.; Fouda, S.M.; Taymour, N.; Akhtar, S.; Khan, S.Q.; Ali, M.S.; Elakel, A.M.; Nassar, E.A.; Gad, M.M. Comparative Evaluation of TiO2 Nanoparticle Addition and Postcuring Time on the Flexural Properties and Hardness of Additively Fabricated Denture Base Resins. Nanomaterials 2023, 13, 3061. [Google Scholar] [CrossRef]
- Gad, M.M.; Abualsaud, R.; Fouda, S.M.; Rahoma, A.; Al-Thobity, A.M.; Khan, S.Q.; Akhtar, S.; Al-Abidi, K.S.; Ali, M.S.; Al-Harbi, F.A. Color Stability and Surface Properties of PMMA/ZrO2 Nanocomposite Denture Base Material after Using Denture Cleanser. Int. J. Biomater. 2021, 2021, 6668577. [Google Scholar] [CrossRef]
- Ren, J.; Lin, H.; Huang, Q.; Zheng, G. Determining color difference thresholds in denture base acrylic resin. J. Prosthet. Dent. 2015, 114, 702–708. [Google Scholar] [CrossRef]
- Schneider, R.L.; Curtis, E.R.; Clancy, J.M.S. Tensile bond strength of acrylic resin denture teeth to a microwave- or heat-processed denture base. J. Prosthet. Dent. 2002, 88, 145–150. [Google Scholar] [CrossRef] [PubMed]
- Pande, N.; Zarekar, S.; Jaiswal, P. Evaluation of shear bond strength of acrylic resin teeth to heat-polymerized denture base resin before and after thermocycling: An in vitro study. Indian J. Multidiscip. Dent. 2018, 8, 25. [Google Scholar]
- Sathish, S.; Lakshmi, S.; Patel, P.; Annapoorni, H. Effect of thermocycling on the micro-tensile bond strength between self-adhesive resin cement and nonphosphate monomer cements on zirconium-oxide ceramics. Indian J. Dent. Res. 2019, 30, 73–79. [Google Scholar]
- Mundorff, S.A.; Little, M.F.; Bibby, B.G. Enamel Dissolution: II. Action of Titanium Tetrafluoride. J. Dent. Res. 1972, 51, 1567–1571. [Google Scholar] [CrossRef] [PubMed]
- Elsaka, S.E.; Elnaghy, A.M.; Mandorah, A.; Elshazli, A.H. Effect of titanium tetrafluoride addition on the physicochemical and antibacterial properties of Biodentine as intraorfice barrier. Dent. Mater. 2019, 35, 185–193. [Google Scholar] [CrossRef]
- Bridi, E.C.; Botelho, A.F.L.; Gomes, F.F.M.; Pedroso, T.C.; Florio, F.M.; Basting, R.T. In Vitro Effects of 2.5% Titanium Tetrafluoride on Streptococcus Mutans and Lactobacillus Casei in Dentin Followed by Self-Etching Adhesive Systems. Eur. J. Prosthodont. Restor. Dent. 2015, 23, 179–186. [Google Scholar]
- de Souza, B.M.; Francisco, E.L.; Braga, A.S.; Santos, P.S.d.S.; Buzalaf, M.A.R.; Magalhães, A.C. In vitro effect of TiF4/NaF solution on the development of radiation-induced dentin caries. J. Appl. Oral Sci. 2024, 32, e20240024. [Google Scholar] [CrossRef]
- van der Linden, R.P.; Dermaut, L.R. White spot formation under orthodontic bands cemented with glass ionomer with or without Fluor Protector. Eur. J. Orthod. 1998, 20, 219–224. [Google Scholar] [CrossRef] [PubMed]
- Shrestha, B.; Mundorff, S.A.; Bibby, B.G. Enamel dissolution: I. Effects of various agents and titanium tetrafluoride. J. Dent. Res. 1972, 51, 1561–1566. [Google Scholar] [CrossRef] [PubMed]
- Chevitarese, A.B.; Leite, K.L.d.F.; Dutra, P.B.; Pithon, M.M.; Faria, L.C.M.; Ruellas, A.C.d.O. Effect of an aqueous 4% titanium tetrafluoride solution on preventing caries in orthodontic patients: A controlled clinical trial. Dent. Press J. Orthod. 2023, 28, e2321304. [Google Scholar] [CrossRef]
- Büyükyilmaz, T.; Øgaard, B.; Duschner, H.; Ruben, J.; Arends, J. The caries-preventive effect of titanium tetrafluoride on root surfaces in situ as evaluated by microradiography and confocal laser scanning microscopy. Adv. Dent. Res. 1997, 11, 448–452. [Google Scholar] [CrossRef]
- Alexandria, A.K.; Nassur, C.; Nóbrega, C.B.C.; Branco-De-Almeida, L.S.; dos Santos, K.R.N.; Vieira, A.R.; Neves, A.A.; Rosalen, P.L.; Valença, A.M.G.; Maia, L.C. Effect of TiF4 varnish on microbiological changes and caries prevention: In situ and in vivo models. Clin. Oral Investig. 2019, 23, 2583–2591. [Google Scholar] [CrossRef]
- Suganthakumar, P.; Reddy, T.V.K.; Venkatesh, V.; Chellapandian, K.; Krishnan, M. Evaluation of the pH and Antibacterial Efficacy of Mineral Trioxide Aggregate with and Without the Incorporation of Titanium Tetrafluoride. Cureus 2024, 16, e64385. [Google Scholar] [CrossRef]
- Tveit, A.B.; Hals, E.; Isrenn, R.; Tøtdal, B. Highly acid SnF2 and TiF4 solutions. Effect on and chemical reaction with root dentin in vitro. Caries Res. 1983, 17, 412–418. [Google Scholar] [CrossRef]
- Wahengbam, P.; Lee, W.B.; Tikku, A. Role of titanium tetrafluoride (TiF4) in conservative dentistry: A systematic review. J. Conserv. Dent. 2011, 14, 98–102. [Google Scholar] [CrossRef] [PubMed]
- Hove, L.; Holme, B.; Stenhagen, K.; Tveit, A. Protective effect of TiF4 solutions with different concentrations and pH on development of erosion-like lesions. Caries Res. 2011, 45, 64–68. [Google Scholar] [CrossRef] [PubMed]
- Pomarico, L.; Villardi, M.; Maia, L.C. In vivo effect of titanium tetrafluoride and sodium monofluorophosphate dentifrice on remineralization: A preliminary split-mouth clinical trial. Gen. Dent. 2012, 60, e249–e254. [Google Scholar]
- Topaloglu-Ak, A.; Cogulu, D.; Ersin, N.K.; Sen, B.H. Microhardness and surface roughness of glass ionomer cements after APF and TiF4 applications. J. Clin. Pediatr. Dent. 2012, 37, 45–51. [Google Scholar] [CrossRef] [PubMed]
- Elsaka, S.E. Effectiveness of Titanium Tetrafluoride on the Bond Strength of Composite Cement to Titanium. J. Adhes. Dent. 2018, 20, 143–149. [Google Scholar] [CrossRef]
- Nascimento, C.G.; Carneiro, R.V.d.T.S.d.M.; Kury, M.; de Moraes, J.P.; Lins, R.B.E.; Cavalli, V. Evaluation of Enamel Surface Properties Submitted to Bleaching with 35% Hydrogen Peroxide Associated with Titanium Tetrafluoride (TiF4). J. Esthet. Restor. Dent. 2025, 37, 505–513. [Google Scholar] [CrossRef]

| Material | Brand Name and Manufacturer Details | Composition |
|---|---|---|
| Heat-polymerized PMMA (HP) | HP, Probase Hot, Ivoclar Vivadent, Lichtenstein | Powder: Polymethyl methacrylate, softening agent, benzoyl peroxide, pigments Liquid: Methyl methacrylate, dimethacrylate (linking agent), catalyst |
| 3D-printed resin | ND, NextDent Denture 3D+, 3D systems, Vertex Dental B.V., Soesterberg, Netherland | Ethoxylated bisphenol A dimethacrylate, 7,7,9(or 7,9,9)-trimethyl-4,13-dioxo-3,14-dioxa-5,12-diazahexadecane-1,16-diyl bismethacrylate, 2-hydroxyethyl methacrylate, Silicon dioxide, diphenyl(2,4,6-trimethylbenzoyl)phosphine oxide, Titanium dioxide |
| Titanium tetrafluoride powder (TiF4) | Aldrich Chemical Company, Milwaukee, WI, USA | Four atoms of fluoride per titanium atom |
| Properties | Mean (SD) | p | ||||
|---|---|---|---|---|---|---|
| HP (Control) | 1HP | 2HP | 3HP | 4HP | ||
| C. albicans (CFU) | 10,233.3 (787.0) a,b,c,d | 247.8 (63.2) a | 284.4 (42.4) b | 271.1 (50.4) c | 0 d | <0.001 * |
| Surface Roughness (Ra, µm) | 0.66 (0.3) | 1.04 (0.01) | 0.33 (0.03) | 1.11 (0.09) | 0.64 (0.03) | 0.062 |
| Hardness (VHN) | 28.0 (3.7) | 28.0 (3.7) | 27.5 (3.5) | 29.5 (3.3) | 27.7 (1.9) | 0.169 |
| Color Change (ΔE00) | ----- | 8.25 (1.35) a | 7.19 (1.6) b | 9.02 (1.59) c | 11.78 (1.38) a,b,c | <0.001 * |
| Properties | Mean (SD) | p | ||||
|---|---|---|---|---|---|---|
| ND (Control) | 1ND | 2ND | 3ND | 4ND | ||
| C. albicans (CFU) | 2566.7 (221.1) | 2780 (272.4) | 2044.4 (870.5) | 2188.9 (108.4) | 2817.8 (118.4) | 0.913 |
| Surface Roughness (Ra, µm) | 1.23 (0.05) a,b | 2.26 (0.05) a,c | 2.51 (0.04) b,d,e | 1.37 (0.04) d,f | 0.39 (0.01) c,e,f | <0.001 * |
| Hardness (VHN) | 24.24 (1.8) a | 27.4 (3.8) b | 34.9 (1.8) a,b,c,d | 26.3 (1.6) c | 26.7 (1.8) d | 0.002 * |
| Color Change (ΔE00) | ----- | 3.91 (0.68) a,b,c | 2.05 (0.36) a,d,e | 5.42 (0.5) b,d,f | 7.89 (0.53) c,e,f | <0.001 * |
Disclaimer/Publisher’s Note: The statements, opinions and data contained in all publications are solely those of the individual author(s) and contributor(s) and not of MDPI and/or the editor(s). MDPI and/or the editor(s) disclaim responsibility for any injury to people or property resulting from any ideas, methods, instructions or products referred to in the content. |
© 2025 by the authors. Licensee MDPI, Basel, Switzerland. This article is an open access article distributed under the terms and conditions of the Creative Commons Attribution (CC BY) license (https://creativecommons.org/licenses/by/4.0/).
Share and Cite
Alzaher, Z.A.; Aldobais, F.A.; Albazroun, Z.; Alatiyyah, F.M.; Abualsaud, R.; Alalawi, H.; Al-Thobity, A.M.; Khan, S.Q.; Gad, M.M. Antifungal Efficacy and Surface Properties of Conventional and 3D-Printed Denture Base Materials Modified with Titanium Tetrafluoride (TiF4): In Vitro Study. Polymers 2025, 17, 1403. https://doi.org/10.3390/polym17101403
Alzaher ZA, Aldobais FA, Albazroun Z, Alatiyyah FM, Abualsaud R, Alalawi H, Al-Thobity AM, Khan SQ, Gad MM. Antifungal Efficacy and Surface Properties of Conventional and 3D-Printed Denture Base Materials Modified with Titanium Tetrafluoride (TiF4): In Vitro Study. Polymers. 2025; 17(10):1403. https://doi.org/10.3390/polym17101403
Chicago/Turabian StyleAlzaher, Zahra A., Fatimah A. Aldobais, Zainab Albazroun, Fatimah M. Alatiyyah, Reem Abualsaud, Haidar Alalawi, Ahmad M. Al-Thobity, Soban Q. Khan, and Mohammed M. Gad. 2025. "Antifungal Efficacy and Surface Properties of Conventional and 3D-Printed Denture Base Materials Modified with Titanium Tetrafluoride (TiF4): In Vitro Study" Polymers 17, no. 10: 1403. https://doi.org/10.3390/polym17101403
APA StyleAlzaher, Z. A., Aldobais, F. A., Albazroun, Z., Alatiyyah, F. M., Abualsaud, R., Alalawi, H., Al-Thobity, A. M., Khan, S. Q., & Gad, M. M. (2025). Antifungal Efficacy and Surface Properties of Conventional and 3D-Printed Denture Base Materials Modified with Titanium Tetrafluoride (TiF4): In Vitro Study. Polymers, 17(10), 1403. https://doi.org/10.3390/polym17101403

